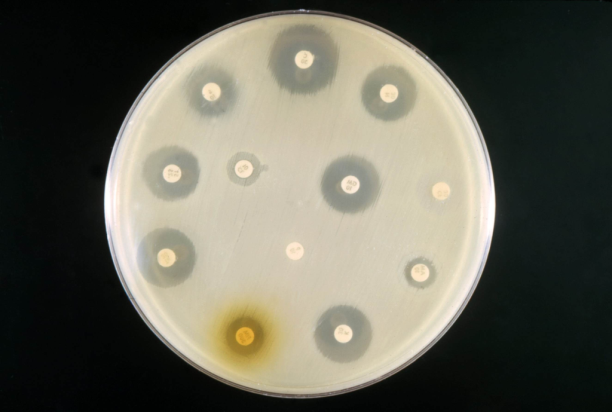
antibiogramma

Ai sensi del d.lgs 196/2003 e del GDPR 679/2016 in merito al trattamento dei dati personali si comunica quanto segue:
Il trattamento dei dati personali sarà improntato come da normativa indicata sui principi di correttezza, liceità, trasparenza e di tutela della Sua riservatezza e dei Suoi diritti. Ai sensi dell'articolo 13 del GDPR 2016/679, pertanto, Le forniamo le seguenti informazioni.
Titolare, responsabili del trattamento dei dati e responsabile della protezione dei dati
Il titolare del trattamento dei dati personali è Cistite.info APS con sede legale in Bolzano Via Parma, 1/C.
Il responsabile del Trattamento personali inseriti in fase di registrazione al forum (https:\\cistite.info\forum), di registrazione alla newsletter (https://vitasananutrizione.info/list/?p=subscribe), di invio di donazioni e/o in fase di richiesta associativa è il Presidente dell'Associazione Cistite.info APS, cui è possibile rivolgersi per esercitare i diritti di cui all'Art. 12 e/o per eventuali chiarimenti in materia di tutela dati personali, è raggiungibile all’indirizzo: cistite.info@pec.it
Tipologia dei dati raccolti
I dati personali (nome, cognome, indirizzo email, indirizzo di residenza, luogo e data di nascita, Codice Fiscale, etc), saranno forniti al momento della richiesta di adesione all'Associazione o in fase di registrazione al forum (https:\\cistite.info\forum) o in fase registrazione alla newsletter (https://vitasananutrizione.info/list/?p=subscribe) o in fase di donazione.
Finalità e modalità del trattamento
I dati personali forniti saranno oggetto:
In relazione ad obblighi legali, fiscali e statutari:
- di trattamento relativo alle finalità istituzionali esercitate dall'Associazione;
- di trattamento finalizzato a rendere possibile la vita associativa nell’Associazione;
- di trattamento relativo alla riscossione e al pagamento di quote di tesseramento, e di iscrizione ad eventi degli eventuali Enti nazionali di affiliazione, anche derivanti da specifici accordi intervenuti con gli stessi;
- di trattamento finalizzato agli obblighi amministrativi, fiscali e contabili dell'Associazione stessa (ivi compresa l'emissione di ricevute, la produzione di certificazioni telematiche, la tenuta del libro degli Associati etc etc).
in relazione a necessità di comunicazione delle attività dell'Associazione, del forum e della newsletter:
- di trattamento connesso alla necessità di comprendere, per il raggiungimento delle comuni finalità istituzionali statutarie, quali siano le attività più idonee per gli associati/tesserati/utenti;
- di trattamento connesso alla necessità di proporre le attività più idonee agli associati/tesserati/utenti;
- di raccolta dati statistici per finalità di studio e ricerca;
- di dare esecuzione al servizio di newsletter aggiornando l'interessato su tutti i progetti, le iniziative, le convenzioni, le informazioni e gli eventi afferenti l'area di competenza, comunque promossi da Cistite.info APS. Il servizio di newsletter verrà erogato tramite strumenti automatizzati.
in relazione a necessità di dar corso alle attività di raccolta fondi come previsto dall’art. 7 dello Statuto:
- di trattamento durante le fasi connesse alla donazione, all’adesione ai progetti e agli appelli promossi dal Titolare, comprese altre attività correlate (es. comunicazioni sui versamenti, riepiloghi di donazione, rendicontazione);
- di trattamento per l’invio di comunicazioni di natura informativa, promozionale e di raccolta fondi relative alle attività e iniziative di Cistite.info APS, con possibile personalizzazione in funzione degli interessi e preferenze manifestate partecipando alle nostre iniziative.
I dati forniti dagli interessati verranno trattati prevalentemente con strumenti informatici sotto l'autorità del titolare del trattamento, da parte di soggetti specificamente incaricati, autorizzati ed istruiti al trattamento dati ai sensi dell’art. 30 del Codice privacy e degli artt. 28 e 29 del Regolamento privacy. Verranno osservate idonee misure di sicurezza anche ai sensi degli artt. 5 e 32 del Regolamento privacy per prevenire la perdita dei dati, usi illeciti o non corretti ed accessi non autorizzati. Tutto ciò per garantire la sicurezza, l'integrità e la riservatezza dei dati stessi nel rispetto delle misure organizzative, fisiche e logiche previste dalle disposizioni vigenti.
Natura obbligatoria o facoltativa del conferimento dei dati, conseguenze di un eventuale rifiuto e base giuridica del trattamento
Si informa che, tenuto conto delle finalità del trattamento come sopra illustrate, il conferimento dei dati è obbligatorio ed il loro mancato, parziale o inesatto conferimento potrà avere, come conseguenza, l'impossibilità di svolgere l’attività dell'Associazione e di assolvere gli adempimenti previsti dallo Statuto stesso nonchè di accedere al forum o di ricevere la newsletter.
A chi e in che ambito il Titolare può trasmettere i dati personali degli Interessati
I dati personali degli Interessati potranno essere comunicati all’interno dell’UE, nel pieno rispetto di quanto previsto dal Codice privacy e dal Regolamento privacy, ai seguenti soggetti:
- alle autorità pubbliche, ove ciò sia imposto dalla legge o su loro richiesta;
- alle strutture e/o società esterne di cui il Titolare si avvale per necessità fiscali e legali e tecnico informatiche e relative alle attività sociali. Tali soggetti, ai quali i dati degli Interessati potranno essere comunicati (in quanto non designati per iscritto Responsabili del trattamento o in quanto non contitolari del medesimo), tratteranno i dati personali degli Interessati in qualità di titolari del trattamento ai sensi della normativa applicabile, in piena autonomia, essendo estranei all’originario trattamento eseguito da Cistite.info APS;
- ai dati succitati non hanno accesso i motori di ricerca (Google, Yahoo, Bing, etc.) quindi non verranno mai indicizzati ne compariranno in essi;
Si informa che i dati dell’associato e le informazioni relative alle loro attività vengono gestiti e archiviati, con idonee procedure, utilizzando piattaforme anche operanti al di fuori del territorio nazionale (anche extra UE), quali Google, Keliweb, etc.
Durata del trattamento
I dati personali vengono conservati per tutta la durata del rapporto di associazione e/o mandato e, nel caso di revoca e/o altro tipo di cessazione del rapporto, nei termini prescrizionali indicati nell’art. 2220 del Codice Civile. Nonostante quanto precede, Cistite.info APS potrà conservare taluni dati personali degli Interessati anche dopo la richiesta di cessazione del trattamento e ciò esclusivamente per difendere o far valere un proprio diritto ovvero nei casi previsti dalla legge o per effetto dell’ordine di un’autorità giudiziale o amministrativa.
Diritti degli interessati
Lei potrà, in qualsiasi momento, esercitare i diritti:
- di accesso ai dati personali;
- di ottenere la rettifica o la cancellazione degli stessi o la limitazione del trattamento che lo riguardano nei casi in cui ciò non confligga con altre disposizioni di legge;
- di opporsi al trattamento;
- di opporsi alla portabilità dei dati;
- di revocare il consenso, ove previsto nei casi in cui ciò non confligga con altre disposizioni di legge: la revoca del consenso non pregiudica la liceità del trattamento basata sul consenso conferito prima della revoca;
- di proporre reclamo all'autorità di controllo (Garante Privacy);
- di confermare l’esistenza o meno dei dati personali degli Interessati, verificarne l’esattezza o richiederne l'aggiornamento e l'integrazione;
L’esercizio dei suoi diritti potrà avvenire attraverso l’invio di una richiesta mediante email all’indirizzo cistite.info@pec.it
Misure di sicurezza
I dati personali degli Interessati sono trattati nel rispetto della legge applicabile ed utilizzando adeguate misure di sicurezza, in ossequio alla normativa in vigore anche ai sensi degli artt. 5 e 32 del Regolamento privacy.
In merito, si conferma, tra l’altro, l’adozione di opportune misure di sicurezza volte ad impedire accessi non autorizzati, furto, divulgazione, modifica o distruzione non autorizzata dei dati degli Interessati.
Modifiche all'informativa privacy
La presente informativa è soggetta a modifiche da parte del Titolare del trattamento; Cistite.info APS comunicherà per email le modifiche agli Interessati, con un preavviso di almeno 15 giorni rispetto alla data in cui si applicherà la nuova informativa.
Regolamento e privacy forum
Rispetto ai dati di registrazione si specifica che:
- l'utilizzo di un nickname consente di mantenere l'anonimato, è pertanto consigliabile non scegliere il proprio nome e cognome come nickname, utilizzando, invece un nome di fantasia;
- i dati di contatto (l'indirizzo di posta elettronica) da fornire all'atto della registrazione al forum non vengono automaticamente pubblicati sul sito stesso unitamente ai commenti dell'utente;
- non vengono richiesti dati che riguardano la salute
- Al fine di stabilire possibili percorsi di cura (per esempio suggerimenti di medici vicini al luogo di residenza dell'utente), l'anno di nascita e la provincia di residenza verrano indicati nel forum, associati esclusivamente al nickname di fantasia indicato dall'utente in fase di registrazione.
Rispetto ai contenuti immessi sul forum l'utente deve valutare con particolare attenzione:
- quanto da lui pubblicato nei post del forum che è liberamente fruibile da chiunque nel web;
- l'opportunità, nei propri interventi, di inserire, o meno, dati personali (indirizzo e-mail, riferimenti a luoghi e persone) che possano rivelarne, anche indirettamente, l'identità;
- l'opportunità di pubblicare, o meno, foto o video che consentano di identificare o rendere identificabili persone e luoghi;
- la possibilità di inserire nei propri interventi dati che possano rivelare, anche indirettamente, l'identità di terzi;
- quanto pubblicato sul forum non verrà cancellato in caso di richiesta di cancellazione dell'account.
Si specifica inoltre che:
- i dati immessi sul forum sono consultabili da qualsiasi utente che accede al sito (reperibilità dei dati mediante funzionalità di ricerca interne al sito);
- i dati immessi sul forum sono indicizzabili e reperibili anche dai motori di ricerca generalisti (Google, etc.),
- Cistite.info APS si riserva il diritto di poter ripubblicare/riutilizzare i dati immessi sul forum in altri media senza consenso dell'utente;
- Cistite.info APS può in ogni momento rimuovere dal forum post indesiderati (ad insindacabile giudizio delle moderatrici e degli amministratori) anche senza preavvisare l'utente;
- le esperienze pubblicate sul sito potranno essere riprodotte con altri mezzi di comunicazione a scopo di studio, ricerca, o divulgativo/informativo anche senza consenso dell'utente.
Informativa tecnica e di servizio
Si fanno inoltre presenti i seguenti punti.
- I sistemi informatici e gli applicativi dedicati al funzionamento di questo Sito rilevano, nel corso del loro normale funzionamento, alcuni dati (la cui trasmissione è implicita nell’uso dei protocolli di comunicazione di Internet) non associati a Utenti direttamente identificabili. Tra i dati raccolti sono compresi gli indirizzi IP e i nomi di dominio dei computer utilizzati dagli Utenti che si connettono al Sito, gli indirizzi in notazione URI (Uniform Resource Identifier) delle risorse richieste, l’orario della richiesta, il metodo utilizzato nel sottoporre la richiesta al server, la dimensione del file ottenuto in risposta, il codice numerico indicante lo stato della risposta data dal server (buon fine, errore, ecc.) ed altri parametri riguardanti il sistema operativo e l’ambiente informatico utilizzato dall’Utente. Questi dati vengono trattati, per il tempo strettamente necessario, al solo fine di ricavare informazioni statistiche anonime sull’uso del Sito e per controllarne il regolare funzionamento. Gli “Amministratori del Sito“ avranno facoltà di servirsi di tali dati per valutazioni statistiche anonime, per assicurare continuità di servizio e per il miglioramento del proprio sito web/forum. Si prega di non usare il servizio se si è in disaccordo con tale prassi.
- L’invio volontario ed esplicito di posta elettronica agli indirizzi indicati di questo Sito e la compilazione dei form (maschere) specificamente predisposti, comportano la successiva acquisizione dell’indirizzo e dei dati del mittente/utente, necessari per rispondere alle istanze prodotte e/o erogare il servizio richiesto. I dati ricevuti dall'utente non verranno memorizzati o utilizzati in altro modo che non sia l'espletamento di quanto contenuto nel messaggio stesso.
- Il Sito consente l'accesso senza l'identificazione/registrazione del visitatore. Per le parti o sezioni del Sito eventualmente soggette a registrazione dei dati personali, verrà appositamente inserita un'informativa e la relativa richiesta di consenso al trattamento dei dati, ai fini del decreto legislativo 196 del 30 giugno 2003 e del GDPR 679/2016.
- Parte di questo sito utilizza i cookies tecnici (non profilanti) per scambiare informazioni tra il server e l'utente. Nessun dato importante viene scambiato tramite cookies. Questo sistema permette l'automazione di alcune operazioni risparmiando procedure complesse all'utente. Inoltre non rappresenta assolutamente un rischio per quest'ultimo.
- Questo sito web utilizza Google Analytics, un servizio di analisi web fornito da Google, Inc. ("Google"). Google Analytics utilizza dei "cookies" (non profilanti), che sono file di testo che vengono depositati sul Vostro computer per consentire al sito web di analizzare come gli utenti utilizzano il sito. Le informazioni generate dal cookie sull'utilizzo del sito web da parte Vostra (compreso il Vostro indirizzo IP) verranno trasmesse a, e depositate presso i server di Google negli Stati Uniti. Google utilizzerà queste informazioni allo scopo di tracciare e esaminare il Vostro utilizzo del sito web, compilare report sulle attività del sito web per gli operatori del sito web e fornire altri servizi relativi alle attività del sito web e all'utilizzo di Internet. Google può anche trasferire queste informazioni a terzi ove ciò sia imposto dalla legge o laddove tali terzi trattino le suddette informazioni per conto di Google. Google non assocerà il vostro indirizzo IP a nessun altro dato posseduto da Google. Potete rifiutarvi di usare i cookies selezionando l'impostazione appropriata sul vostro browser, ma ciò potrebbe impedirvi di utilizzare tutte le funzionalità di questo sito web. Utilizzando il presente sito web, voi acconsentite al trattamento dei Vostri dati da parte di Google per le modalità e i fini sopraindicati.
- CISTITE.INFO potrà utilizzare l'indirizzo e-mail fornito dall'utente per l'invio di messaggi informativi, strettamente legati al sito e ai servizi offerti. L'utente può richiede la cessazione di queste comunicazioni andando all'indirizzo http://vitasananutrizione.info/list/?p=unsubscribe&id=1</a> oppure scrivendo all'indirizzo amministratore@cistite.info.
- CISTITE.INFO può attivare qualsiasi meccanismo di protezione contro l'abuso dello spam, per controllare che la consultazione del sito del forum e la registrazione al forum siano realmente effettuate da esseri umani e non da software robots o similari, per verificare anche in maniera automatica, che non vengano inseriti post ,commenti, ecc considerati spam. Pertanto potranno essere attivati meccanismi di verifica dell'indirizzo ip, della email o del nome utente anche tramite riscontri incrociati con altri database.